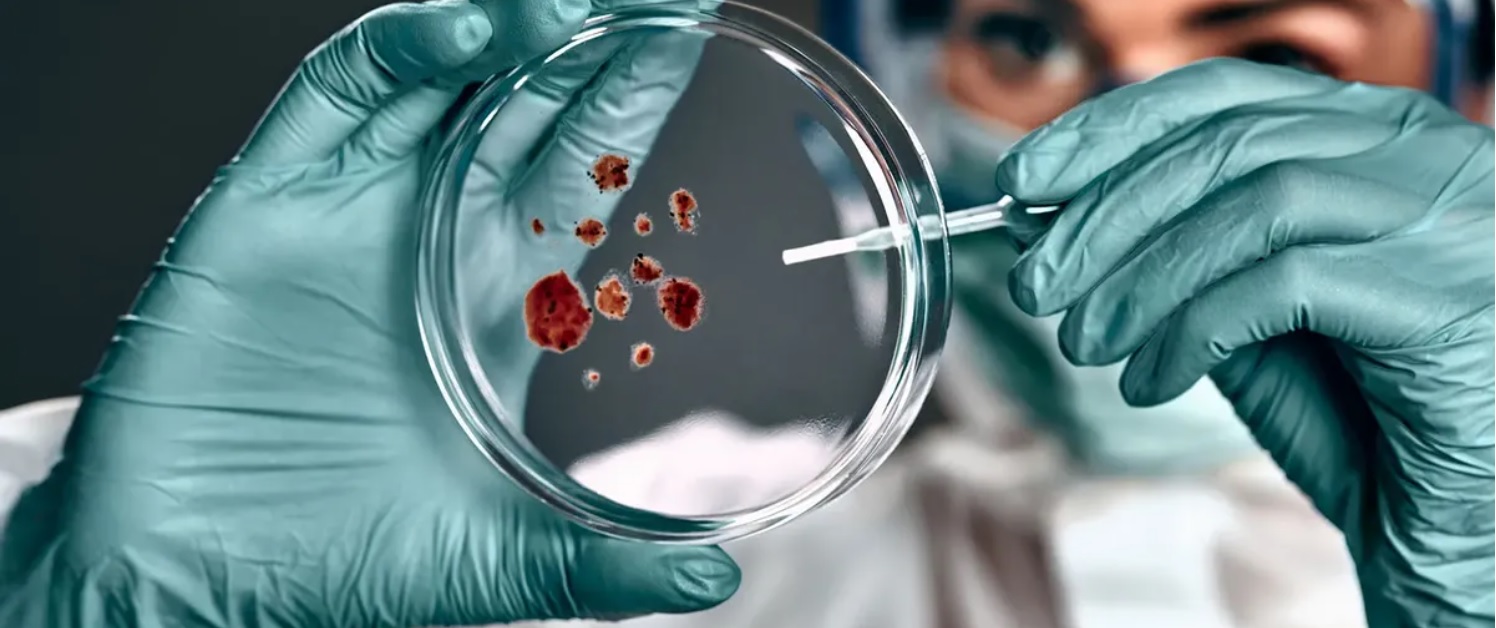
Virusul care este pe cale sa declanseze o noua epidemie in lume

Virusul care este aproape să declanşeze o nouă epidemie în lume. Virusul Zika este pe cale să sufere o mutație, iar noua variantă ar putea face ravagii, au avertizat experții. În 2015 și 2016, a făcut ravagii în special în rândul copiilor, provocând leziuni cerebrale unui număr foarte mare de bebeluși. Mamele lor fuseseră infectate în timpul sarcinii, ceea ce le-a afectat dezvoltarea.
Virusul care este pe cale să declanşeze o nouă epidemie în lume
Virusul este răspândit de țânțari, care se găsesc mai ales în America și Asia. Ultima mare epidemie a început în Brazilia, deși primele cazuri au fost observate în Africa în 1947. Numărul de cazuri a scăzut dramatic în ultimii ani, dar virusul reprezintă încă o problemă „semnificativă” pe termen lung, potrivit Organizației Mondiale a Sănătății, scrie The Sun.
Recentele avertismente au fost lansate din cauza temerilor că virusul ar putea suferi cu ușurință mutații, generând astfel noi variante. Cercetătorii din SUA au tras un semnal de alarmă și au îndemnat lumea să fie foarte atentă la acest aspect.
În cazul în care variantele apar și se răspândesc, ar putea cauza probleme chiar și în țările care au fost imunizate în urma unor focare anterioare, au avertizat oamenii de știință în revista Cell Reports.
O echipă de la Institutul de imunologie La Jolla a descoperit că rezultatele obținute prin transmiterea virusului de la țânțari la șoareci sugerează că ar putea fi create cu ușurință noi variante.
„Varianta Zika pe care am identificat-o a evoluat până în punctul în care imunitatea de protecție încrucișată oferită de o infecție anterioară cu dengue (virus care provoacă febra denga – n.r.) nu mai era eficientă la șoareci.
Din nefericire pentru noi, dacă această variantă devine răspândită, am putea avea aceleași probleme în viața reală”, a declarat profesorul Sujan Shresta, cercetătorul principal al studiului.
Cu toate acestea, poate fi transmisă și pe cale sexuală, virusul putând rămâne în sperma unui bărbat infectat timp de luni de zile.
Ce simptome prezintă persoana infectată cu Zika
În general, virusul provoacă doar o infecție foarte ușoară și doar o cincime dintre persoanele infectate devin bolnave în mod vizibil. Dar adevăratul pericol este pentru cei cu un sistem imunitar slăbit și pentru femeile însărcinate, deoarece poate fi transmis de la mamă la copil.
Zika a fost legat de afecțiunea neurologică sindromul Guillain-Barré, care poate provoca paralizie. De asemenea, acest virus este responsabil de microcefalie la copii, o malformație congenitală care îi face să se nască cu un cap anormal de mic și cu un creier dezvoltat incomplet.
Deși există un vaccin în curs de dezvoltare, cel mai bun mod de a vă proteja împotriva acestui virus este să evitați să fiți mușcați de țânțari. Simptomele includ o erupție cutanată, mâncărimi, dureri articulare, febră, dureri de cap și dureri în partea inferioară a spatelui.